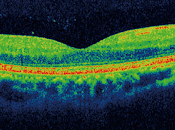
Glaucoma nuevas tecnologías.

Beatrizmayoral
 Descripción
Descripción
compartido
MIS BLOGS
- Beatriz Mayoral http://beatrizmayoral.blogspot.com/
ÚLTIMOS ARTÍCULOS (787)
-
Estudio encuentra que la obesidad incrementa el riesgo de astigmatismo en...

Escrito por Selina Powell para Optometry Today.Un nuevo estudio publicado en The Open Ophthalmology Journal ha explorado la relación entre obesidad y... Leer el resto
Publicado el 10 junio 2026 SALUD Y BIENESTAR -
Ejercicios oculares para mejorar la visión.

Escrito por Dr. Benjamin Botsford de Umass Chan Medical School.Existen anuncios que promueven la terapia visual para eliminar la necesidad de usar lentes. Leer el resto
Publicado el 03 junio 2026 SALUD Y BIENESTAR -
Cuidados tras una operación de cataratas.

El cuidado postoperatorio tras una cirugía de cataratas es fundamental para una correcta cicatrización y evitar infecciones. Aplicar estrictamente las gotas de... Leer el resto
Publicado el 20 mayo 2026 SALUD Y BIENESTAR -
Claves para una visión saludable.

Cuidar los ojos puede ayudar a prevenir la pérdida de visión por glaucoma y otras enfermedades. Un examen completo de la vista puede detectar enfermedades de... Leer el resto
Publicado el 13 mayo 2026 SALUD Y BIENESTAR -
Apnea y glaucoma.

Escrito por Anju Goyal para Academia Americana de Oftalmología.Cuando una persona tiene apnea obstructiva del sueño (AOS)1 debe saber que dejarla sin tratamient... Leer el resto
Publicado el 22 abril 2026 SALUD Y BIENESTAR -
Qué tan seguido debo ver al médico si tengo glaucoma?

Escrito por Arsham Sheybani para Glaucoma Research Foundation. Los exámenes regulares de la vista son esenciales para personas diagnosticadas con glaucoma a... Leer el resto
Publicado el 15 abril 2026 SALUD Y BIENESTAR -
De la hojita del calendario.

El hombre sabio no se sienta a lamentarse, sino que se pone alegremente a su tarea de reparar el daño hecho.Séneca Imagen de Leer el resto
Publicado el 01 abril 2026 SALUD Y BIENESTAR -
Conceptos sobre miopía.

La miopía crece más durante el invierno y menos durante el verano. No se sabe si es por el incremento del trabajo escolar, la disminución de la luz solar, o el... Leer el resto
Publicado el 25 marzo 2026 SALUD Y BIENESTAR -
Desprendimiento de vítreo posterior.

El desprendimiento de vítreo posterior es la separación del vítreo (la gelatina transparente que llena el globo ocular) de su normal sujeción a la retina. Leer el resto
Publicado el 18 marzo 2026 SALUD Y BIENESTAR -
Revisión de la miopía.

Zylbermann et al (The influence of study habits on myopia in Jewish teenagers) analizaron la incidencia de miopía en dos grupos: estudiantes judíos ortodoxos... Leer el resto
Publicado el 11 marzo 2026 SALUD Y BIENESTAR -
Criterios sobre cirugía refractiva.

Un procedimiento LASIK exitoso está determinado por si el paciente cumple ciertos criterios ya que no todo mundo es buen candidato para una cirugía refractiva. Leer el resto
Publicado el 04 marzo 2026 SALUD Y BIENESTAR -
De la hojita del calendario

No es a la muerte a lo que el hombre debe temer, sino a no empezar a vivir. Marco Aurelio Imagen de Leer el resto
Publicado el 25 febrero 2026 SALUD Y BIENESTAR -
Salud mental y glaucoma.

La pérdida visual asociada a glaucoma puede tener un fuerte impacto en la salud mental. Recientes estudios indican que ciertos aspectos de la salud mental,... Leer el resto
Publicado el 18 febrero 2026 SALUD Y BIENESTAR -
La presión sanguínea y el glaucoma.

La presión sanguínea tanto alta como baja puede afecta la salud ocular.Para saber si la presión sanguínea está relacionada con el glaucoma, puede decirse, que... Leer el resto
Publicado el 11 febrero 2026 SALUD Y BIENESTAR -
Glaucoma secundario a cirugía de cataratas.

Escrito por Robert Feldman para Glaucoma Research Foundation. El glaucoma secundario a cirugía de cataratas GSCC es una forma de glaucoma que frecuentemente se... Leer el resto
Publicado el 31 diciembre 2025 SALUD Y BIENESTAR -
Hipertensión sistémica y circulación retiniana.

Los efectos de la hipertensión arterial afectan principalmente las arterias pequeñas. La mayor parte de los vasos retinianos son de pequeño calibre (300 μm o... Leer el resto
Publicado el 24 diciembre 2025 SALUD Y BIENESTAR -
Mejorar el cumplimiento de los pacientes en el tratamiento del glaucoma.

El glaucoma es la causa mas común de pérdida irreversible de la visión a nivel mundial. El tipo mas comun de glaucoma es el glaucoma primario de ángulo abierto... Leer el resto
Publicado el 17 diciembre 2025 SALUD Y BIENESTAR -
Cuando se tienen cataratas y glaucoma.

Los pacientes que tienen tanto cataratas como glaucoma requieren de una atención especial. Las cataratas y el glaucoma pueden presentarse juntos de manera... Leer el resto
Publicado el 10 diciembre 2025 SALUD Y BIENESTAR -
Ver destellos y puntos flotando puede indicar una separación de vítreo o...

En personas que se presenten al optometrista con molestias como ver destellos o puntos flotantes deben hacerse varias pruebas como toma de agudeza visual, prueb... Leer el resto
Publicado el 03 diciembre 2025 SALUD Y BIENESTAR -
Glaucoma y nuevas tecnologías.
La campimetría o examen del campo visual, ha sido durante mucho tiempo el patrón de referencia para evaluar el estado del glaucoma. Leer el resto
Publicado el 19 noviembre 2025 SALUD Y BIENESTAR
